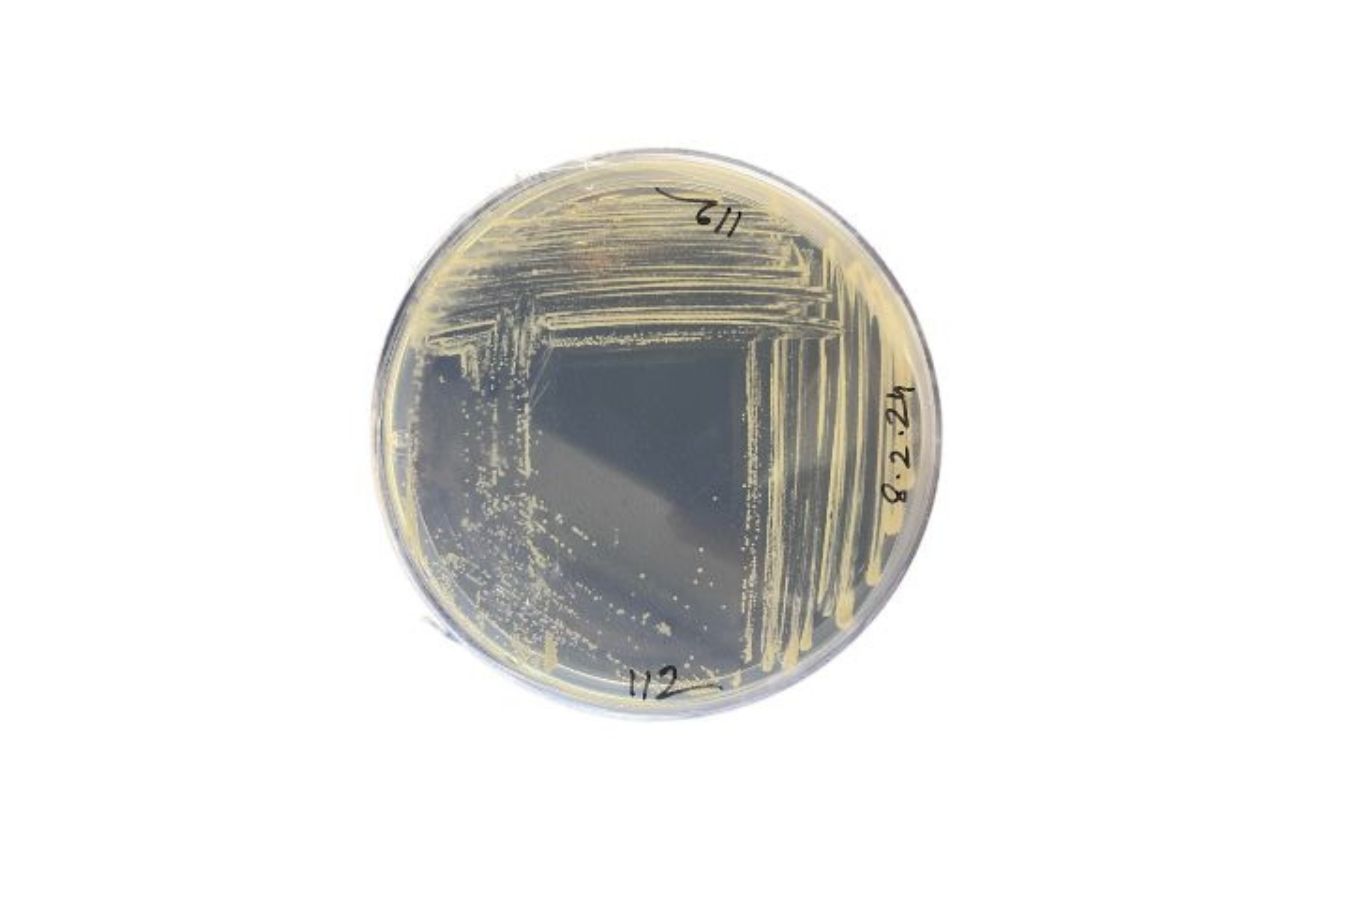

Abban mindenki egyetért, hogy komfortosabb úgy kilépni a zuhany alól vagy a kádból, ha kellemes meleg van a fürdőszobában, különösen ősszel és télen, amikor azért is állunk be a meleg víz alá, hogy felmelegítsen.
A napi tisztálkodási rutinnak helyet adó fürdőben rendszerint lenge öltözetben vagy ruha nélkül tartózkodunk, ezért mindennél fontosabb, hogy olyan hőmérséklet fogadjon, amiben nem didergünk. Kényelmünk érdekében fontoljuk meg törölközőszárító radiátor beszerzését a Zuhanykabin.hu webáruházból. Ezek a fűtőtestek azonban nemcsak a hőmérséklet növelését hivatottak elősegíteni, hanem a törölközők szárítását is lehetővé teszik, továbbá stílusos kiegészítői az enteriőröknek. Választásnál tehát többféle szempontot kell mérlegelni, nem dönthetünk csak az esztétika alapján.
Kellemes meleg a fürdőszobában
Nemcsak télen, a fűtési szezonban vágyunk kellemes hőmérsékletre fürdés után, hanem a hűvös tavaszi és őszi estéken is jól eshet a fürdővízzel megyező melegbe kilépni. Nem beszélve azokról az alkalmakról, amikor lazítás vagy feltöltődés céljával hosszabban időzünk itt, vagy romantikus fürdőzést tervezünk a párunkkal.
De jó lehet akkor is, ha kisbaba vagy kisgyerekek vannak a családban. A kiegészítő fűtés segítségével pillanatnyi igényeink szerint gyorsan befűthetjük a tisztálkodás szentélyét, így nem kell a központi fűtésre várni, illetve olyan időszakban is megoldható a probléma, amikor az nem működik.
A különféle, akár dizájnos megjelenésű radiátorok hozzájárulnak, hogy a fürdőszoba ne csak funkcionálisan jól használható, hanem esztétikus és otthonos is legyen.
Hogyan válasszunk?
A legtöbb fürdőszobába elegendő lehet a kellemes hőmérséklet biztosításához törölközőszárító radiátort elhelyezni, hiszen megfelelő teljesítmény mellett be tudja fűteni a helyiséget. A méretezést azonban bízzuk szakemberre, aki a helyiség méretét, adottságait figyelembe véve kiválasztja számunkra a megfelelő teljesítményű modellt. Fontos, hogy be lehessen kötni a meglévő fűtési rendszerbe, ehhez ismerni kell a szükséges csatlakozási és bekötési formát.
A fűtőtest esztétikai megjelenése, színe, formája, kialakítása egyéni preferencia kérdése, amelyről a fürdőszoba stílusa alapján magunknak kell dönteni. A hagyományos törölközőszárító radiátorok diszkréten belesimulnak a környezetükbe, a speciális kialakítású, gyönyörű megjelenésű dizájn modellek pedig különleges darabjai lesznek a fürdőknek, egyedi hangulatot teremtenek.
Találd meg a legjobb megoldást!
Az ideális fűtőtest kiválasztása nem is olyan könnyű, tekintve, hogy óriási választék áll rendelkezésre. A megfelelő méret nemcsak a teljesítmény, hanem a helyiség használhatósága, berendezése szempontjából is lényeges. Nagy fürdőkben természetesen nem okoz problémát, de szűkös helyiségekben bizony alapos mérlegelést kíván.
Vásárolhatunk egyenes vagy íves kivitelt, jellemzően fehér, krómozott, esetleg fekete színben, de egyes típusoknál lehetőség van akár 20 színárnyalatból is választani.
Kapcsolj ki! További friss híreket talál az oxox.hu főoldalán! Kövesse a technológiai híreket és csatlakozzon hozzánk a Facebookon is!